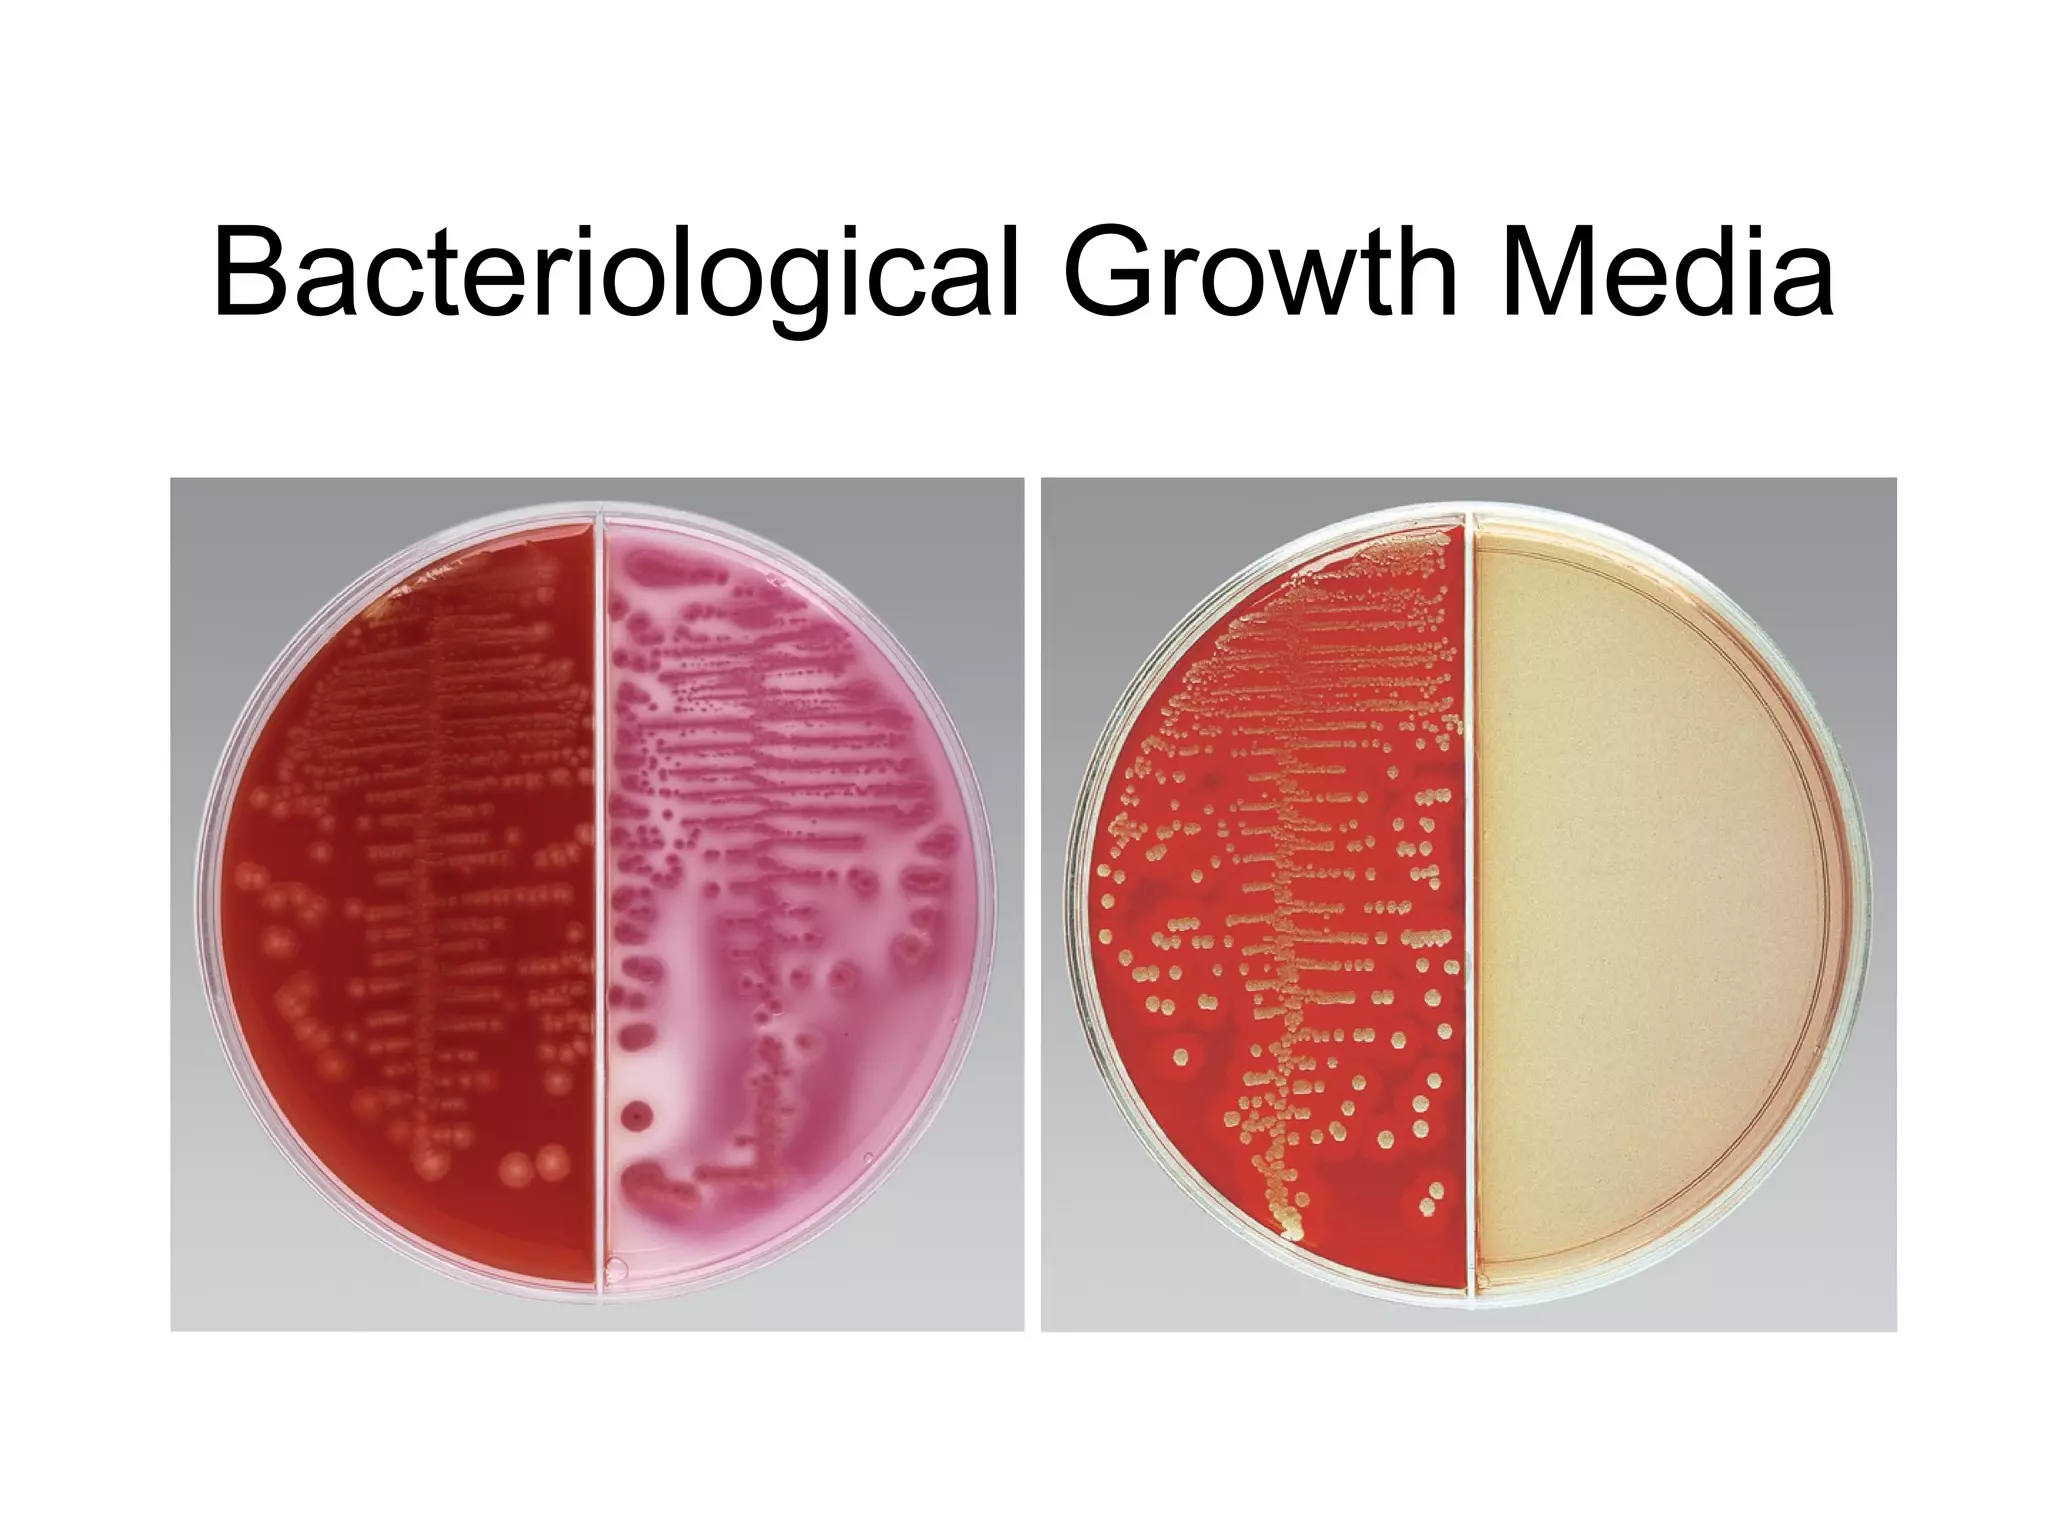
Bacteriological Growth Media
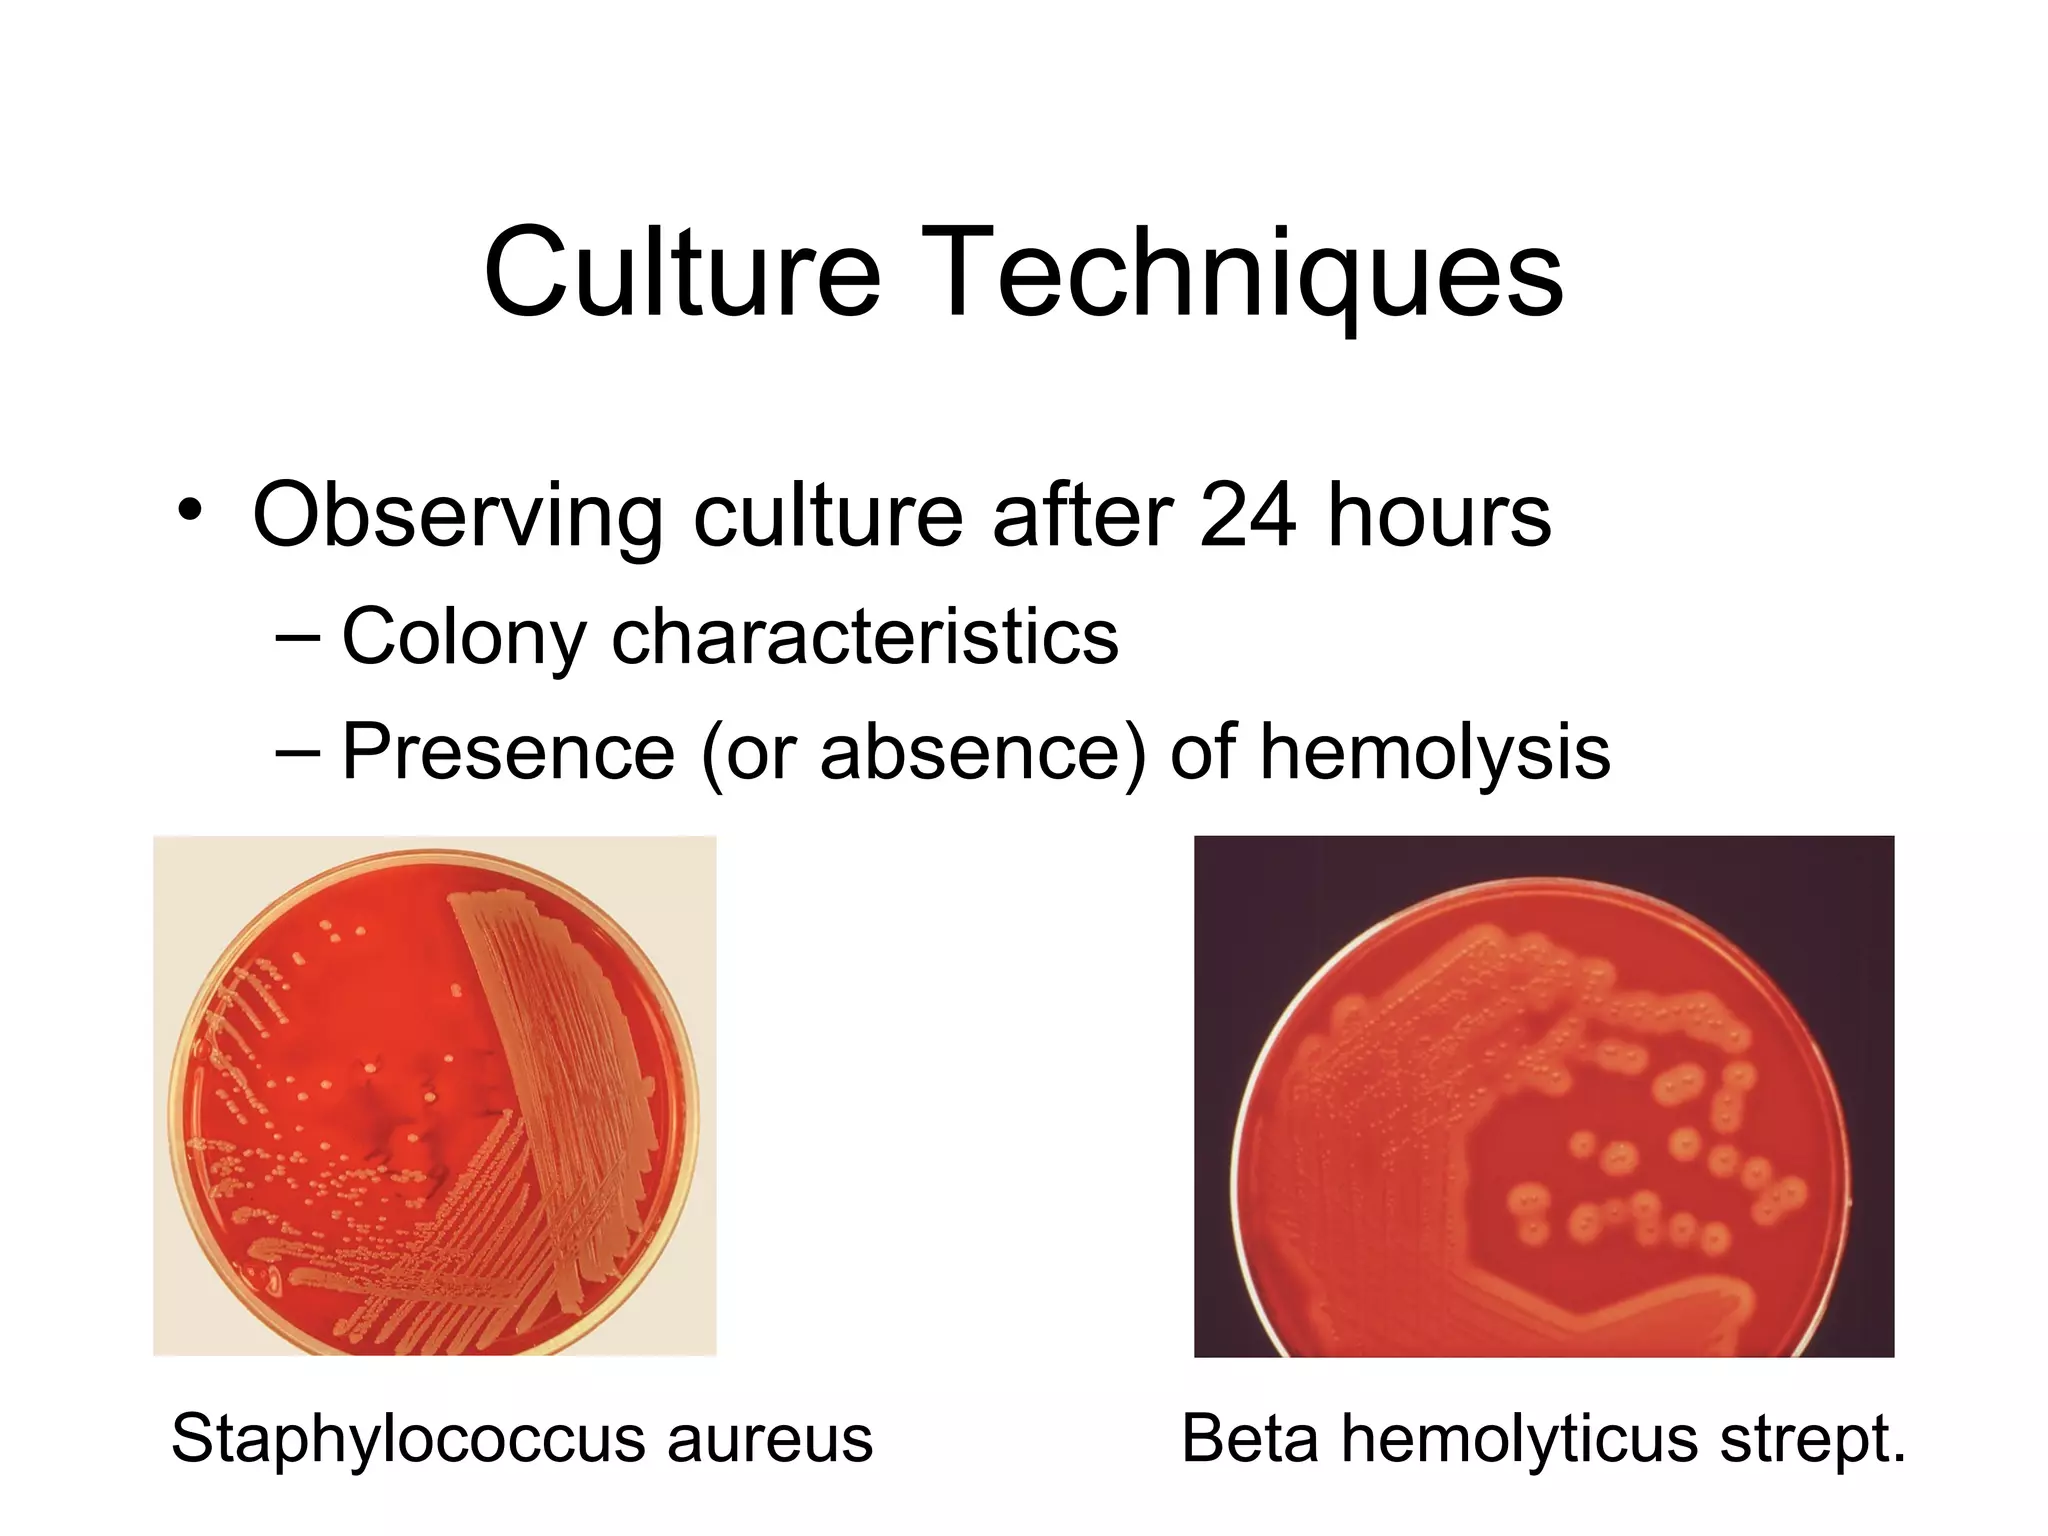
Culture Techniques Observing culture after 24 hours Colony characteristics Presence (or absence) of hemolysis Staphylococcus aureus  Beta hemolyticus strept.

Microbiology encompasses the study of bacteria, parasites, viruses, and fungi. Bacteriology includes identifying bacterial characteristics, appropriate specimen collection, aseptic technique, culture techniques, colony characteristics, gram staining, and common bacterial infections like bacteremia, meningitis, and those caused by Staphylococcus, Streptococcus, Enterococcus, Candida, Cryptococcus, and E. coli. Identification requires observing bacterial growth, morphology, hemolysis, gram reaction, and automated methods.